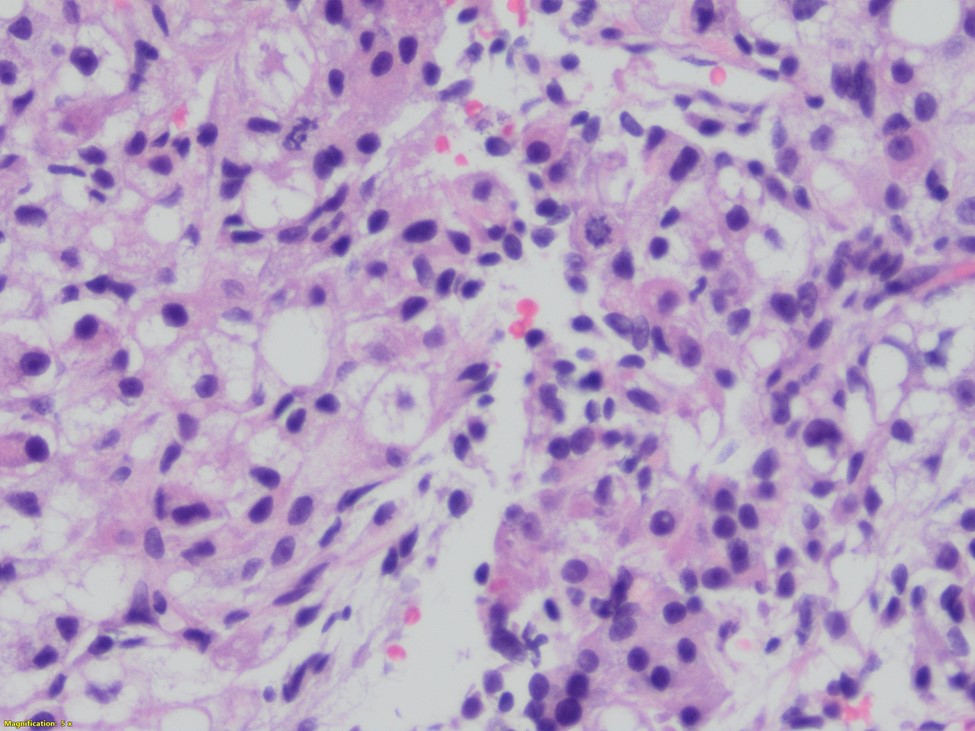
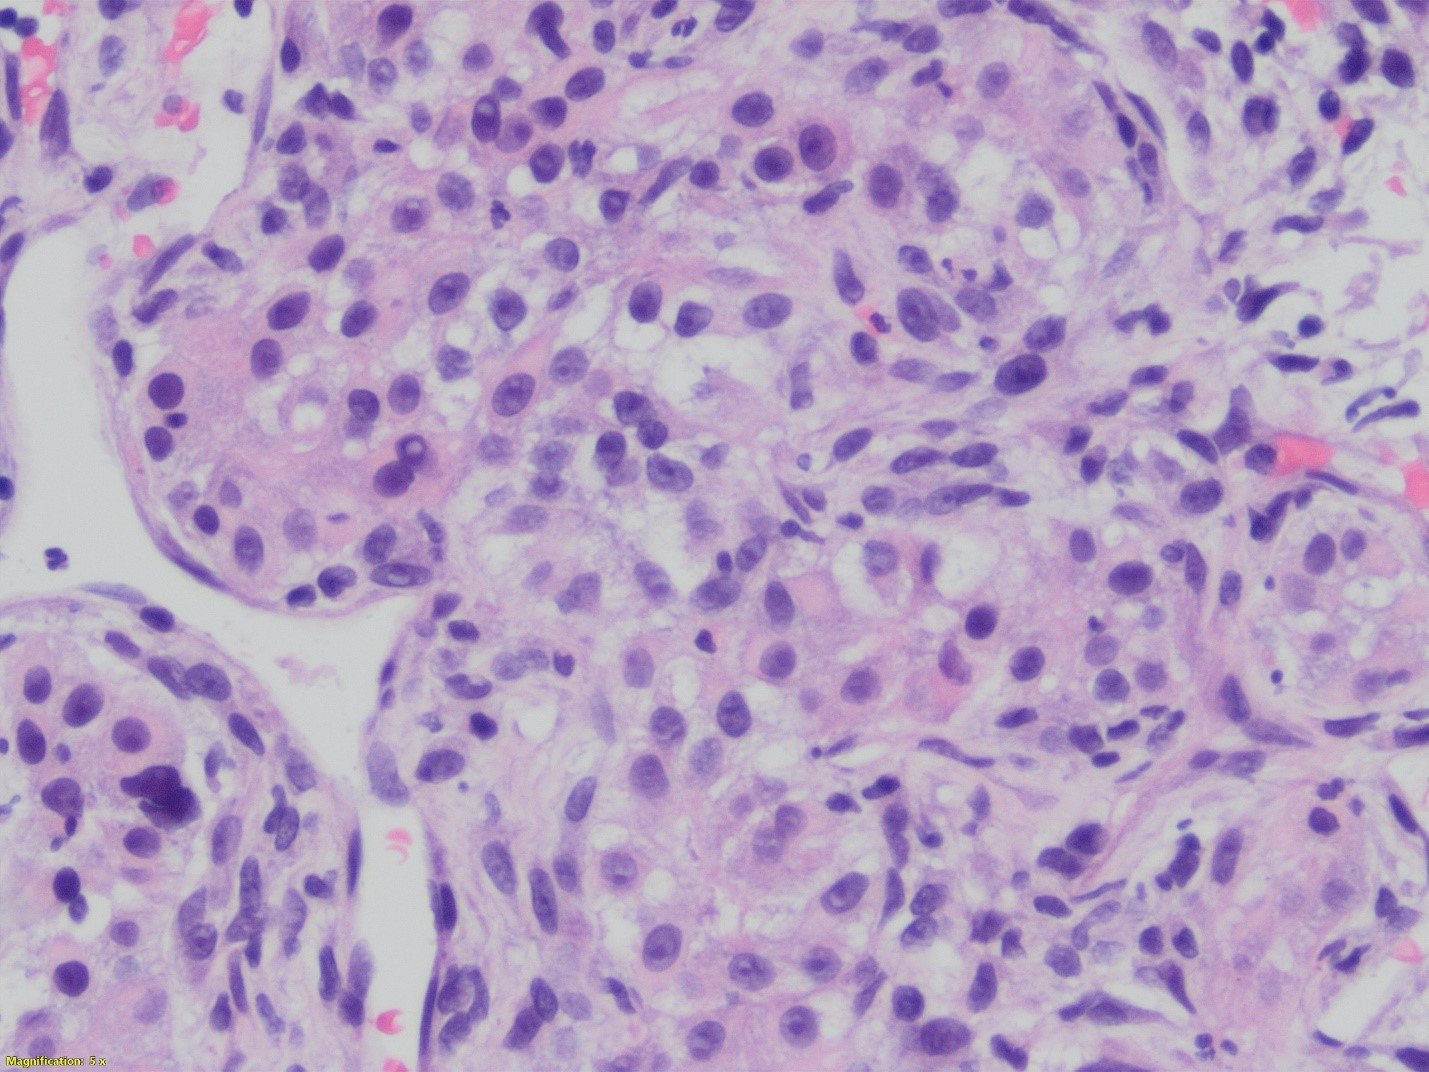

Case History
A 57-year-old man presented with dysphagia, hoarseness of voice, wt. loss and mass in the left thyroid lobe. Needle biopsy performed at an outside institution with pathologic diagnosis of liposarcoma vs. unusual thyroid carcinoma. Immunostains were focally positive for keratin and negative for S100, CD34 and TTF-1. Stains performed at our institution were negative for keratin, Ca9, RCC, Pax8, chromogranin and faintly positive for synaptophysin.
Based on the histology and stains what is the most likely diagnosis?
- Liposarcoma
- Anaplastic thyroid carcinoma
- Metastatic clear cell carcinoma
- Sarcomatoid parathyroid carcinoma

Answer: D. Sarcomatoid parathyroid carcinoma




Explanation:
This unusual biphasic tumor has both carcinomatous and spindle cell component. The carcinomatous component is formed of granular, clear and markedly anaplastic cells. In some areas, the architecture recapitulates parathyroid differentiation: chief cells and oxyphil cells-like clusters. The areas that are poorly differentiated shows spindle and clear cell component. Keratin stain demonstrated the biphasic nature of the lesion. The tumor is positive for synaptophysin, and negative for calcitonin, Pax8, TTf-1, Sox10, and HMB45. Based on these immunostains and focal parathyroid differentiation a diagnosis of carcinoma with sarcomatoid features favoring parathyroid origin was rendered.
